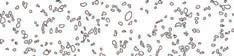
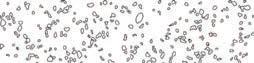
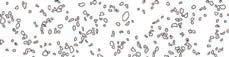
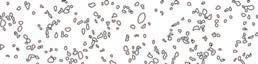

MIREYA BALLESTEROS
PORTFOLIO


























![]()


























PROJECT RESPONSIBILITIES
PFA & Contaminant Research
Conceptual Design
Site Specific Design
PROJECT DESCRIPTION
This project proposes a landscape based remediation strategy for an area impacted by PFAS, TCE, and related contaminants associated with the Tucson International Airport Superfund site. Located near Drexel Road and Tucson Boulevard, the design integrates phytoremediation plantings, bioretention basins, and constructed wetlands to intercept contaminated runoff and support long term groundwater recovery. The landscape functions as both ecological infrastructure and public space, using native Sonoran Desert vegetation, protective buffers, and pathways to ensure safety while restoring habitat. The site functions as a living system that addresses environmental injustice, supports community health, and demonstrates how landscape architecture can contribute to Superfund remediation and collective healing.



- Establishes deep roots to begin reaching contaminated
- Starts phytostabilizing contaminants like heavy metals
- Promotes rhizodegradation through root exudates support-
- Establishes deep roots to begin reaching contaminated
- Starts phytostabilizing contaminants like heavy metals
- Promotes rhizodegradation through root exudates support-
- Begins filtering contaminants from shallow groundwater and stormwater runoff - Supports microbial breakdown of VOCs.
- Supports long-term riparian ecosystem health.
- Begins filtering contaminants from shallow groundwater and stormwater runoff
- Supports microbial breakdown of VOCs.

- Forms
- Stabilizes soil and reduces erosion near contamination hotspots
- Long-term stabilizer, creating conditions for deeper-rooted plants to remediate
-mMature root systems contribute to longterm soil detoxification and water filtration

- Supports long-term riparian ecosystem health.

- Stabilizes soil and reduces erosion near contamination hotspots - Long-term stabilizer, creating conditions for deeper-rooted plants to remediate


- Forms dense root mats that filter out contaminants in shallow soil layers -mMature root systems contribute to longterm soil detoxification and water filtration


- Provides early-stage nitrogen fixation, enhancing soil health and microbial activity

- Mature tree improves soil bioremediation processes over a wider are
- Expands phytostabilization of heavy metals in surrounding soil
- Provides early-stage nitrogen fixation, enhancing soil health and microbial activity
- Mature tree improves soil bioremediation processes over a wider are

- Expands phytostabilization of heavy metals in surrounding soil







- Begins stabilizing riparian areas by reducing erosion near contaminated runoff
- Uptakes shallow contaminants like VOCs from stormwater basins
- Begins stabilizing riparian areas by reducing erosion near contaminated runoff
- Mature tree handles larger volumes of water, removing VOCs and other soluble contaminants.
- Uptakes shallow contaminants like VOCs from stormwater basins


- Begins accumulating salts and heavy metals in above-ground tissues

- Continues absorbing and stabilizing salts and metals over time
- Begins accumulating salts and heavy metals in above-ground tissues
- Enhances soil by preventing further contamination spread
- Continues absorbing and stabilizing salts and metals over time

- Mature tree handles larger volumes of water, removing VOCs and other soluble contaminants.
- Enhances soil by preventing further contamination spread






































Freshly planted tree roots reach from a few inches to a foot deep

directly intercept contaminated groundwater halting further contamination

PROJECT RESPONSIBILITIES
Green Infrastructure Calculations
Watershed Inventory & Analysis
Climate Analysis & Interpretation
PROJECT DESCRIPTION
This project applies a green infrastructure framework to the grounds of Parroquia de La Sagrada Familia in Nogales, Sonora to address site scale hydrological dysfunction, environmental justice concerns, and the need for culturally responsive public space. The schematic design evaluates existing drainage patterns and runoff contributions from adjacent impervious surfaces and proposes an integrated system of bioswales, rain gardens, infiltration basins, and permeable circulation to improve the overall function. From a social ecological perspective, the design positions the church grounds as critical community infrastructure within an undeserved border context by coordinating circulation, gathering spaces, and GI elements to ensure access, legibility of stormwater processes, and culturally grounded environmental education that links hydrological function with community identity.

This map showcases urban areas of Ambos Nogales (highlighted in pink) along with potential green infrastructure (GI) sites
The green areas represent locations deemed suitable for green infrastructure implementation based on a land suitability analysis
Solid green zones indicate identified Green Infrastructure Sites, where GI interventions such as bioswales, permeable surfaces, and riparian restoration projects may be prioritized
This map expands on the previous one by illustrating a broader network of suitable areas for GI development across Ambos Nogales
Green areas cover a larger extent, showing a more detailed assessment of where green infrastructure can be implemented effectively



















Species List:









Outdoor Amphitheater
Events Flex Space
Gathering Area






























Secluded Gathering
Secluded Gathering

































Multi-use Court
Solitude Garden
Terraced Vegetation































Shaded Parking










Community Garden



































PROJECT RESPONSIBILITIES
Indigenous Research & Philosophy
Community Collaboration
Conceptual Design of NTU Campus
Site Specific Design
PROJECT DESCRIPTION
Working in partnership with Navajo Technical University (NTU), NTU’s student Sustainability Club, and an MLA studio from the University of New Mexico (UNM), students conducted a transformative and re-imagined vision for the NTU campus in Crownpoint, NM. The project addressed stormwater challenges and supported climate resilience while affirming Diné values through culturally informed green infrastructure and spatial or programmatic interventions that respect water as a central component in the socio environmental health of the campus and campus community. Particular attention will be given to healing the campus landscape through a reciprocal design process that engages NTU students, faculty, staff, and community members as co-creators.

Existing Site Context






The masterplan highlights opportunities for design interventions that respond to a number of challenges encountered on the NTU Campus.

This section cut shows the plant details of the medicinal garden, highlighting which native plants have healing properties as well as their mature sizes.



This section cut shows the terracing of the bioswale, designed to capture, infiltrate, and slow rainwater using green infrastructure techniques


Leading Community Workshops
Installing Cisterns & Passive Water Harvesting Landscapes
Maintenance of GSI Landscapes
Creating Informational Graphics
In this internship I was an Urban Sustainable Living intern. I helped lead multiple community workshops, teaching about how to design and build water harvesting landscapes in the desert. I learned how to install water harvesting designs in residential yards and grew my understanding for GSI design and plant selection.

During my internship, I assisted with WMG’s Water Harvesting Certification Course, developing green infrastructure at Pio Decimo Center in Tucson.

